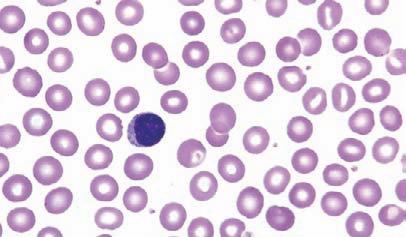
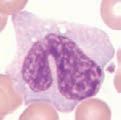
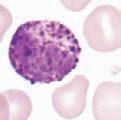
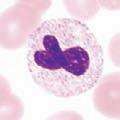
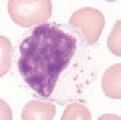

https://ebookmass.com/product/clinical-hematology-atlas-5thedition/
Instant digital products (PDF, ePub, MOBI) ready for you
Download now and discover formats that fit your needs...
Clinical Hematology Atlas 6th Edition Jacqueline H. Carr
https://ebookmass.com/product/clinical-hematology-atlas-6th-editionjacqueline-h-carr/
ebookmass.com
Clinical Hematology: Theory & Procedures Sixth Edition
https://ebookmass.com/product/clinical-hematology-theory-proceduressixth-edition/
ebookmass.com
Atlas of Diagnostic Hematology 1at Edition Mohamed Salama (Editor)
https://ebookmass.com/product/atlas-of-diagnostic-hematology-1atedition-mohamed-salama-editor/
ebookmass.com
Radiant Sin Katee Robert
https://ebookmass.com/product/radiant-sin-katee-robert-10/
ebookmass.com
Blackmist: A LitRPG Adventure (My Best Friend is an Eldritch Horror Book 1) Actus
https://ebookmass.com/product/blackmist-a-litrpg-adventure-my-bestfriend-is-an-eldritch-horror-book-1-actus/
ebookmass.com
Mastering Technical Sales: The Sales Engineer's Handbook 4th Edition John Care
https://ebookmass.com/product/mastering-technical-sales-the-salesengineers-handbook-4th-edition-john-care/
ebookmass.com
Dog Grooming For Dummies 2nd Edition Margaret H. Bonham
https://ebookmass.com/product/dog-grooming-for-dummies-2nd-editionmargaret-h-bonham/
ebookmass.com
Technical Analysis Explained, Fifth Edition : The Successful Investoru2019s Guide
https://ebookmass.com/product/technical-analysis-explained-fifthedition-the-successful-investors-guide/
ebookmass.com
Some Like It Kilted (The Ravenscraig Legacy Book 4) Sue Ellen Welfonder
https://ebookmass.com/product/some-like-it-kilted-the-ravenscraiglegacy-book-4-sue-ellen-welfonder/
ebookmass.com
Seduced by the Mountain Man: A Mountain Man/Curvy Woman
Short Instalove Romance (Men of Big Horn Ridge Book 4) 1st
Edition Carly Keene
https://ebookmass.com/product/seduced-by-the-mountain-man-a-mountainman-curvy-woman-short-instalove-romance-men-of-big-horn-ridgebook-4-1st-edition-carly-keene/ ebookmass.com
CONTENTS Section1 Introduction
1IntroductiontoPeripheralBloodFilmExamination1
Section2 Hematopoiesis
2Hematopoiesis11
3ErythrocyteMaturation17
4MegakaryocyteMaturation31
5NeutrophilMaturation41
6MonocyteMaturation55
7EosinophilMaturation65
8BasophilMaturation75
9LymphocyteMaturation79
Section3 Erythrocytes
10VariationsinSizeandColorofErythrocytes89
11VariationsinShapeandDistributionofErythrocytes93
12InclusionsinErythrocytes107
13DiseasesAffectingErythrocytes115
Section4 Leukocytes
14NuclearandCytoplasmicChangesinLeukocytes131
15AcuteMyeloidLeukemia139
16PrecursorLymphoidNeoplasms157
17MyeloproliferativeNeoplasms161
18MyelodysplasticSyndromes171
19MatureLymphoproliferativeDisorders181
20MorphologicChangesafterMyeloidHematopoieticGrowthFactors191
Section5 Miscellaneous
21Microorganisms195
22MiscellaneousCells203
23NormalNewbornPeripheralBloodMorphology215
24BodyFluids219
Glossary 241
Appendix:ComparisonTables 261 Index 265
Clinical Hematology Atlas EvolveStudentResourcesforRodak: ClinicalHematologyAtlas, 5thedition includethefollowing:
• AdditionalPhotosforIdentification
• StudentReviewQuestions
• SummaryTables
Activatethecompletelearningexperiencethatcomeswitheach textbookpurchasebyregisteringat http://evolve.elsevier.com/Rodak/
Clinical Hematology Atlas BernadetteF.Rodak,MS,MT(ASCP)SH
ProfessorEmeritus
ClinicalLaboratoryScienceProgram
DepartmentofPathologyandLaboratoryMedicine
IndianaUniversitySchoolofMedicine Indianapolis,Indiana
JacquelineH.Carr,MS,MT(ASCP)SH
FormerLaboratoryManager
DepartmentofPathologyandLaboratoryMedicine
IndianaUniversityHealth Indianapolis,Indiana
3251RiverportLane St.Louis,Missouri63043
CLINICALHEMATOLOGYATLAS,FIFTHEDITIONISBN:978-0-323-32249-2
Copyright © 2017byElsevier,Inc.Allrightsreserved.
Nopartofthispublicationmaybereproducedortransmittedinanyformorbyanymeans,electronicor mechanical,includingphotocopying,recording,oranyinformationstorageandretrievalsystem,without permissioninwritingfromthepublisher.Detailsonhowtoseekpermission,furtherinformationaboutthe Publisher’spermissionspoliciesandourarrangementswithorganizationssuchastheCopyrightClearance CenterandtheCopyrightLicensingAgency,canbefoundatourwebsite: www.elsevier.com/permissions
ThisbookandtheindividualcontributionscontainedinitareprotectedundercopyrightbythePublisher (otherthanasmaybenotedherein).
Notices Knowledgeandbestpracticeinthisfieldareconstantlychanging.Asnewresearchandexperiencebroaden ourunderstanding,changesinresearchmethods,professionalpractices,ormedicaltreatmentmaybecome necessary.
Practitionersandresearchersmustalwaysrelyontheirownexperienceandknowledgeinevaluatingand usinganyinformation,methods,compounds,orexperimentsdescribedherein.Inusingsuchinformation ormethodstheyshouldbemindfuloftheirownsafetyandthesafetyofothers,includingpartiesforwhom theyhaveaprofessionalresponsibility.
Withrespecttoanydrugorpharmaceuticalproductsidentified,readersareadvisedtocheckthemost currentinformationprovided(i)onproceduresfeaturedor(ii)bythemanufacturerofeachproducttobe administered,toverifytherecommendeddoseorformula,themethodanddurationofadministration,and contraindications.Itistheresponsibilityofpractitioners,relyingontheirownexperienceandknowledgeof theirpatients,tomakediagnoses,todeterminedosagesandthebesttreatmentforeachindividualpatient, andtotakeallappropriatesafetyprecautions.
Tothefullestextentofthelaw,neitherthePublishernortheauthors,contributors,oreditors,assumeanyliability foranyinjuryand/ordamagetopersonsorpropertyasamatterofproductsliability,negligenceorotherwise,or fromanyuseoroperationofanymethods,products,instructions,orideascontainedinthematerialherein.
Previouseditionscopyrighted2013,2009,2004,and1999.
InternationalStandardBookNumber: 978-0-323-32249-2
LibraryofCongressCataloging-in-PublicationData Rodak,BernadetteF.,author. Clinicalhematologyatlas/BernadetteF.Rodak,JacquelineH.Carr. –Fifthedition. p.;cm. Includesindex.
ISBN978-0-323-32249-2(pbk.:alk.paper) I.Carr,JacquelineH.,author.II.Title.
[DNLM:1.HematologicDiseases–diagnosis–Atlases.2.HematologicDiseases–pathology–Atlases.WH17] RB145 616.1'5–dc23
2015036694
ExecutiveContentStrategist: KellieWhite
ContentDevelopmentManager: LaurieGower
ContentDevelopmentSpecialist: KarenTurner
PublishingServicesManager: JulieEddy
ProjectManager: AbigailBradberry
DesignDirection: JuliaDummitt
PrintedinChina
Lastdigitistheprintnumber: 987654321
Toourhusbands, RobertHartman and CharlesCarr, daughters, KimberlyCarrMayrose and AlexisCarr, andallofourcolleagueswhohaveencouragedus tocontinuetopublishthisatlasinitsconciseformat
REVIEWERS StevenMarionneux,MS,MT(ASCP) Manager,ClinicalHematologyLaboratories MemorialSloanKetteringCancerCenter
NewYork,NewYork
AdjuctAssistanceProfessor,ClinicalLaboratorySciences Rutgers,TheStateUniversityofNewJersey Newark,NewJersey
AlisaJ.Petree,MHSM,MLS(ASCP)cm Professor/ClinicalCoordinator McLennanCommunityCollege Waco,Texas
PREFACE Becausetheemphasisofanatlasismorphology,the ClinicalHematologyAtlas isintended tobeusedwithatextbook,suchas Rodak’sHematology,fifthedition,thataddresses physiologyanddiagnosisalongwithmorphology.Thisatlasisdesignedforadiverse audiencethatincludesclinicallaboratorysciencestudents,medicalstudents,residents,and practitioners.Itisalsoavaluableresourceforclinicallaboratorypractitionerswhoarebeing retrainedorcross-trainedinhematology.Itisnotintendedtobeadetailed,comprehensive manualfordiagnosis.
Inthisconciseformat,everyphotomicrographandwordhasbeenevaluatedforvalueto themicroscopist.Allsuperfluousinformationhasbeenexcludedinanattempttomaintain focusonsignificantmicroscopicfindingswhilecorrelatingthisinformationwithclinicaldiagnosis.WhatstartedasaprimerforClinicalLaboratorySciencestudentswithnoprevious hematologyeducationhasevolvedintoaninternationallyrecognizedreferenceformultiple levelsofexpertise,fromentryleveltopracticingprofessionals.
ORGANIZATION Asisfrequentlyexpounded,morphologyonaperipheralbloodfilmisonlyasgoodasthe qualityofthesmearandthestain. Chapter1 reviewssmearpreparation,staining,andthe appropriateareainwhichtoevaluatecelldistributionandmorphology.Atablethatsummarizesthemorphologyofleukocytesfoundinanormaldifferential,alongwithmultipleexamplesofeachcelltype,facilitatesearlyinstructioninbloodsmearreview.
Chapter2 schematicallypresentshematopoieticfeaturesofcellmaturation.Generalcell maturation,alongwithanelectronmicrographwithlabeledorganelles,willhelpreaderscorrelatethesubstructureswiththeappearanceofcellsunderlightmicroscopy.Visualizingnormalcellularmaturationisessentialtotheunderstandingofdiseaseprocesses.Thiscorrelation ofschematic,electronmicrograph,andWright-stainedmorphologyiscarriedthroughoutthe maturationchapters. Figure2-1 hasbeenformattedtoreflectrecenthematopoietictheory.In addition,thechartaidsreadersinrecognizingtheanatomicalsitesatwhicheachstageofmaturationnormallyoccurs.
Chapters3to9 presentthematurationofeachcelllineindividually,repeatingtherespectivesegmentoftheoverallhematopoieticschemefrom Chapter2,toassistthestudentinseeingtherelationshipofeachcelllinetothewhole.Inthesechapters,eachmaturationstageis presentedasacolorprint,aschematic,andanelectronmicrograph.Adescriptionofeachcell, includingoverallsize,nuclear-to-cytoplasmicratio,morphologicfeatures,andreference rangesinperipheralbloodandbonemarrow,servesasaconvenientsummary.Thefinalfigure ineachofthesechapterssummarizeslineagematurationbyrepeatingthehematopoieticsegmentwiththecorrespondingphotomicrographs.Multiplenomenclaturesforerythrocyte maturationareusedtoaccommodateuseinmultiplesettingsanddemographicgroups.
Chapters10to12 presentdiscretecellularabnormalitiesoferythrocytes,thatis,variations insize,color,shape,anddistribution,aswellasinclusionsfoundinerythrocytes.Eachvariationispresentedalongwithadescriptionoftheabnormality,orcompositionoftheinclusion,andassociateddisorders.
Becausediseasesareoftencombinationsofthecellularalterations, Chapter13 integrates morphologicfindingsintothediagnosticfeaturesofdisordersprimarilyaffectingerythrocytes.
In Chapter14,nuclearandcytoplasmicchangesinleukocytesaredisplayedandcorrelated withnon-malignantleukocytedisorders.
Diseasesofexcessiveoralteredproductionofcellsmaybecausedbymaturationarrest, asynchronousdevelopment,orproliferationofonecellline,aspresentedin Chapters15 to19.Cytochemicalstainsarepresentedwithdisordersinwhichtheyareuseful.
Thetherapeuticuseofmyeloidgrowthfactorscausesmorphologicchangesthatmimic severeinfectionsormalignancies. Chapter20 presentsexamplesofperipheralbloodmorphologyfollowingG-CSForGM-CSF.Itistheauthors’ designthatthecellulardefectsinleukocytedisordersbevisuallycomparedwiththeprocessofnormalhematopoiesisforamore thoroughcomprehensionofnormalandaltereddevelopment.Readersareencouragedto refertothenormalhematopoiesisillustration, Figure2-1,forcomparisonofnormaland abnormalcellsandtheprogressionofdiseases.
Microorganisms,includingparasites,maybeseenonperipheralbloodsmears.Abriefphotographicoverviewisgivenin Chapter21.Readersareencouragedtoconsultamicrobiology reference,suchasMahonCM,LehmanDC,ManuselisG: TextbookofDiagnosticMicrobiology, fifthedition,foramoredetailedpresentation.
Chapter22 includesphotomicrographsthatarenotcategorizedintoanyoneparticular area,suchasfatcells,mitoticfigures,metastatictumorcells,andartifacts.
Chapter23 describesfindingsexpectedintheperipheralbloodofneonates,including anticipatedvariationsinmorphologyandcellulardistribution.Comparisonofthehematogone,normalfornewborns,withtheblastcellofacuteleukemiaisincluded.
Chapter24 isintendedtobeanoverviewofthemostfrequentmicroscopicfindingsin bodyfluids.Itisnotproposedasacomprehensivereviewofthecytologyofhumanbody fluids,butratheraquickreferenceforthebeginningmicroscopistaswellastheseasoned professional.
Aswiththethirdeditionandfourtheditions,thefiftheditionfeaturesspiralbinding,makingtheatlasmoreconvenientwhenusedatthemicroscopebench.
Allofthesechapterscombineintowhatwebelieveisacomprehensiveandvaluable resourceforanyclinicallaboratory.Thequalityoftheschematicillustrations,electronmicrographs,andcolorphotographsstandforthemselves.Wehopethatthisatlaswillenrichthe learningprocessforthestudentandserveasanimportantreferencetoolforthepractitioner.
EVOLVE TheEvolvewebsiteprovidesfreematerialsforbothstudentsandinstructors.Instructorshave accesstoanelectronicimagecollectionfeaturingalloftheimagesfromtheatlas.Studentsand instructorshaveaccesstosummarytables,studentreviewexercises,andadditionalphotosfor identification.
BernadetteF.Rodak JacquelineH.Carr
ACKNOWLEDGMENTS Frominceptiontocompletionwehavehadagreatdealofassistanceandencouragement fromthefacultyandstaffoftheDepartmentofPathologyandLaboratoryMedicine, IndianaUniversitySchoolofMedicine.Thefollowingindividualshave “gonethe extramile” tohelpuscontinuetorealizeourdream: GeorgeGirgis,MT(ASCP),forsharing hisincrediblecollectionofbodyfluidslidesandhisexpertiseinbothbloodcellandbodyfluid morphology; LindaMarler and JeanSiders fortheirtechnicalassistancewithdigital photographyanddigitalediting;and LindaMarler and CarlaClem,facultymembersin theClinicalLaboratoryScienceprogram,fortheirsupportandpatienceduringthisendeavor. Carlaalsoprovidedauthoritativecommentsonimagesandhelpedusdeterminewhichimages wereclassicexamples.Aparticularthankyougoesouttoourfamiliesfortheirunderstanding duringthemanyhoursthatwespentawayfromthemwhilepursuingthisgoal.
AspecialthankyougoestotheprofessionalsatElsevierwhonavigatedusthrough theproductionofthisatlas.Wewouldespeciallyliketothank LaurieGower, Content DevelopmentManager, KarenTurner, ContentDevelopmentSpecialist, Rebecca Corradetti, DevelopmentalEditoratSpringHollowPress, AbigailBradberry,Project Manager,and JulieEddy,PublishingServicesManager.
CHAPTER1 INTRODUCTIONTOPERIPHERAL BLOODFILMEXAMINATION Aproperlypreparedbloodfilmisessentialtoaccurateassessmentofcellularmorphology.Avarietyofmethodsareavailableforpreparingandstainingbloodfilms,the mostcommonofwhicharediscussedinthisatlas.Itisbeyondthescopeofthisatlas todiscussothermethodologies;however,detaileddescriptionsoftheseprocedurescanbe foundintextbooksonhematology,suchasKeohane,Smith,andWalenga’ s Rodak’sHematology:ClinicalPrinciplesandApplications
WEDGEFILMPREPARATION MAKINGTHEPERIPHERALBLOODFILM Althoughsomeautomatedanalyzersprepareandstainbloodfilmsaccordingtoestablished criteria,manualbloodfilmpreparationisstillusedinmanyplaces.Thewedgefilmisaconvenientandcommonlyusedtechniqueformakingperipheralbloodfilms.Thistechnique requiresatleasttwo3 1-inch(75 25-mm)cleanglassslides.High-quality,beveled-edge microscopeslidesarerecommended.Oneslideservesasthebloodfilmslide,andtheother asthespreaderslide.Thesecanthenbereversedtoprepareasecondfilm.Adropofethylenediaminetetraaceticacid(EDTA)anticoagulatedbloodabout3mmindiameterisplaced atoneendoftheslide.Alternatively,asimilarsizedropofblooddirectlyfromafingeror heelpunctureisacceptable.Thesizeofthedropofbloodisimportant.Toolargeadrop createsalongorthickfilm,andtoosmalladropoftenmakesashortorthinfilm.Inpreparingthefilm,thetechnicianholdsthepusherslidesecurelyinfrontofthedropofbloodat a30-to45-degreeangletothefilmslide(Figure1-1, A).Thepusherslideispulledback intothedropofbloodandheldinthatpositionuntilthebloodspreadsacrossthewidthof theslide(Figure1-1, B).Itisthenquicklyandsmoothlypushedforwardtotheendofthe filmslide,creatingawedgefilm(Figure1-1, C).Itisimportantthatthewholedropofblood ispickedupandspread.Movingthepusherslideforwardtooslowlyaccentuatespoorleukocytedistributionbypushinglargercells,suchasmonocytesandgranulocytes,tothevery endsandsidesofthefilm.Maintainingaconsistentanglebetweentheslidesandaneven, gentlepressureisessential.Itisfrequentlynecessarytoadjusttheanglebetweentheslidesto produceasatisfactoryfilm.Forhigherthannormalhematocrit,theanglebetweentheslides mustbeloweredsothatthefilmisnottooshortandthick.Forextremelylowhematocrit, theanglemustberaised.Awell-madeperipheralbloodfilm(Figure1-2)hasthefollowing characteristics:
1.Abouttwo-thirdstothree-fourthsofthelengthoftheslideiscoveredbythefilm.
2.Itisslightlyroundedatthefeatheredge(thinportion),notbulletshaped.
3.Lateraledgesofthefilmshouldbevisible.Theuseofslideswithchamfered(beveled)cornersmayfacilitatethisappearance.
4.Itissmoothwithoutirregularities,holes,orstreaks.
5.Whentheslideishelduptolight,thefeatheredgeofthefilmshouldhavea “rainbow” appearance.
6.Thewholedropispickedupandspread.
Figure1-3 showsexamplesofunacceptablefilms.
C FIGURE1–1 Wedgetechniqueofmakingaperipheralbloodfilm. A,Correctangletoholdspreaderslide. B,Bloodspreadacrosswidthofslide. C,Completedwedgefilm. (FromKeohaneE.A.,SmithL.,WalengaJ.(Eds.)(2016). Rodak’shematology:clinicalprinciples andapplications.(5thed.).St.Louis:SaundersElsevier.)
FIGURE1–2 Well-madeperipheral bloodfilm.
(FromKeohaneE.A.,SmithL.,WalengaJ. (Eds.)(2016). Rodak’shematology:clinical principlesandapplications.(5thed.). St.Louis:SaundersElsevier.)
FIGURE1–3 Unacceptableperipheralbloodfilms.Slideappearancesassociatedwiththemostcommon errorsareshown,butnotethatacombinationofcausesmayberesponsibleforunacceptablefilms. A,Chippedorroughedgeonspreaderslide. B,Hesitationinforwardmotionofspreaderslide. C,Spreaderslidepushedtooquickly. D,Dropofbloodtoosmall. E,Dropofbloodnotallowedtospread acrossthewidthoftheslide. F,Dirtorgreaseontheslide;mayalsobecausedbyelevatedlipidsin thebloodspecimen. G,Unevenpressureonthespreaderslide. H,Timedelay;dropofbloodbegantodry. (FromKeohaneE.A.,SmithL.,WalengaJ.(Eds.)(2016). Rodak’shematology:clinicalprinciplesand applications.(5thed.).St.Louis:SaundersElsevier.)
STAININGOFPERIPHERALBLOODFILMS Thepurposeofstainingbloodfilmsistoidentifycellsandrecognizemorphologyeasily throughthemicroscope.WrightorWright-Giemsastainsarethemostcommonlyused forperipheralbloodandbonemarrowfilms.Thesestainscontainbotheosinandmethylene blueandarethereforetermed polychromestains.Thecolorsvaryslightlyfromlaboratoryto laboratory,dependingonthemethodofstaining.
Slidesmustbeallowedtodrythoroughlybeforestaining.Thecellsarefixedtotheglass slidebythemethanolinthestain.StainingreactionsarepHdependent,andtheactual stainingofthecellularcomponentsoccurswhenabuffer(pH6.4)isaddedtothestain.Free methyleneblueisbasicandstainsacidiccellularcomponents,suchasRNA,blue.Freeeosin isacidicandstainsbasiccomponents,suchashemoglobinoreosinophilicgranules,red. NeutrophilshavecytoplasmicgranulesthathaveaneutralpHandacceptsomecharacteristicsfrombothstains.Detailsforspecificmethodsofstainingperipheralbloodandbone marrowfilms,includingautomatedmethods,maybefoundinastandardtextbookof hematology.
Anoptimallystainedfilm(Figure1-4)hasthefollowingcharacteristics:
1.Theredbloodcells(RBCs)shouldbepinktosalmon.
2.Nucleiaredarkbluetopurple.
3.Cytoplasmicgranulesofneutrophilsarelavendertolilac.
4.Cytoplasmicgranulesofbasophilsaredarkbluetoblack.
5.Cytoplasmicgranulesofeosinophilsareredtoorange.
6.Theareabetweenthecellsshouldbecolorless,clean,andfreeofprecipitatedstain.
Awell-stainedslideisnecessaryforaccurateinterpretationofcellularmorphology.Thebest stainingresultsareobtainedfromfreshlymadeslidesthathavebeenpreparedwithin2to 3hoursofbloodcollection. Box1-1 listscommonreasonsforpoorlystainedslidesand maybeusedasaguidewhentroubleshooting.
FIGURE1–4 Optimallystainedperipheralblood filmdemonstratingtheappropriateareainwhichto performthewhitebloodcelldifferentialand morphologyassessmentandtheplateletestimate. Onlythecenterofthefieldisshown;anentirefield wouldcontain200to250redbloodcells (original 1000).
BOX1-1 TroubleshootingPoorlyStainedBloodFilms FirstScenario
Problems
• Redbloodcellsappeargray
• Whitebloodcellsaretoodark
• Eosinophilgranulesaregray,notorange Causes
• Stainorbuffertooalkaline(mostcommon)
• Inadequaterinsing
• Prolongedstaining
• Heparinizedbloodsample
SecondScenario
Problems
• Redbloodcellstoopaleorredcolor
• Whitebloodcellsbarelyvisible Causes
• Stainorbuffertooacidic(mostcommon)
• Underbuffering(timetooshort)
• Over-rinsing
FromKeohaneE.A.,SmithL.,WalengaJ.(Eds.)(2016). Rodak’ s hematology:clinicalprinciplesandapplications.(5thed.). St.Louis:SaundersElsevier.
PERIPHERALFILMEXAMINATION 10 × EXAMINATION
Examinationofthebloodfilmisamultistepprocess.Beginthefilmexaminationwithascanof theslideusingthe10 orlow-powerobjective(totalmagnification ¼ 100 ).Thisstepisnecessarytoassesstheoverallqualityofthefilm,includingabnormaldistributionofRBCs,suggestingthepresenceofrouleauxorautoagglutination,and/orthepresenceofadisproportionate numberoflargenucleatedcellssuchasmonocytesorneutrophilsattheedgesofthefilm.If thelatterexists,anotherfilmshouldbeprepared.Inaddition,the10 filmexaminationallows fortherapiddetectionoflargeabnormalcellssuchasblasts,reactivelymphocytes,andparasites.
40 × OR50 × EXAMINATION Usingthe40 (highdry)objectiveorthe50 oilobjective(400 and500 totalmagnification,respectively),findanareaofthefilminwhichtheRBCsareevenlydistributedand barelytouchingoneanother(twoorthreecellsmayoverlap; Figure1-5).Scaneighttoten fieldsinthisareaofthefilm,anddeterminetheaveragenumberofwhitebloodcells(WBCs) perfield.Althoughanexactfactorvarieswiththemakeandmodelofmicroscope,ingeneral, anapproximateWBCcountpercubicmillimetercanbedeterminedbymultiplyingtheaveragenumberofWBCsperhigh-powerfieldby2000(if40 isused),or2500(if50 isused).
FIGURE1–5 Correctareaofbloodfilmin whichtoevaluatecellulardistributionand performwhitebloodcellestimate( 400).
Thisestimateisausefulquality-controltoolforvalidatingWBCcountsfromhematology analyzers.AnydiscrepancybetweentheinstrumentWBCcountandtheslideestimatemust beresolved.SomereasonsfordiscrepanciesincludethepresenceofWBCorplateletclumps, fibrinstrands,severeRBCagglutination,cryoprecipitate,andgiantplatelets,inadditiontoa mislabeledfilm,afilmmadefromthewrongpatient’ssample,andaninstrumentmalfunction.
100 × EXAMINATION ThenextstepinfilmevaluationistoperformtheWBCdifferential.Thisisdoneinthesamearea ofthefilmastheWBCestimatebutusingthe100 oilimmersionobjective(1000 totalmagnification).WhenthecorrectareaofthefilmfromapatientwithanormalRBCcountisviewed, about200to250RBCsperoilimmersionfieldareseen(see Figure1-4).Characteristically,the differentialcountincludescountingandclassifying100consecutiveWBCsandreportingthese classesaspercentages.Thedifferentialcountisperformedinasystematicmannerusingthe “battlement” track(Figure1-6),whichminimizesWBCdistributionerrors.Theresultsarereported aspercentagesofeachtypeofWBCseenduringthecount.AnexampleofaWBCdifferential countis3%bands,55%segmentedneutrophils,30%lymphocytes,6%monocytes,4%eosinophils,and2%basophils(Table1-1).AnyWBCabnormalities,suchastoxicchanges,D€ ohlebodies,reactivelymphocytes,andAüerrods,arealsoreported.Whenpresent,nucleatedredblood cells(NRBCs)arecountedandreportedasnumberofNRBCsper100WBCs.TheRBC, WBC,plateletmorphologyevaluation,andplateletestimatesarealsoperformedunderthe 100 oilimmersionobjective.RBCinclusions,suchasHowell-Jollybodies,andWBC
FIGURE1–6 ”Battlement” patternfor performingawhitebloodcelldifferential. (FromKeohaneE.A.,SmithL.,WalengaJ. (Eds.)(2016). Rodak’shematology:clinical principlesandapplications.(5thed.). St.Louis:SaundersElsevier.)
Segmented neutrophil (Seg),polymorphonuclear neutrophil (Poly,PMN)
Band neutrophil (Band)
10to 15 2to5lobes connectedby thinfilaments withoutvisible chromatin
Coarsely clumped
Palepink, cream colored,or colorless
10to 15 Constricted,but chromatinmust bevisiblewithin thethinnestpart Coarsely clumped Paleblueto pink
Lymphocyte (Lymph)
7to 18* Roundtooval; maybeslightly indented; occasional nucleoli
Monocyte (Mono)
Eosinophil (Eos)
12to 20 Variable;may beround, horseshoe,or kidneyshaped; oftenhasfolds producing “brainlike” convolutions
12to 17 2to3lobes connectedby thinfilaments withoutvisible chromatin
Basophil (Baso)
10to 14 Usuallytwo lobesconnected bythinfilaments withoutvisible chromatin
Condensedto deeply condensed
Scantto moderate; skyblue
Moderately clumped;lacy Blue-gray; mayhave pseudopods; vacuolesmay beabsentor numerous
Manyfinegranules, frequentlygiving theappearanceof groundglass
Coarsely clumped Creamto pink;may haveirregular borders 1
:Rare 2
:Abundantredto orange,round
3to110.5to1.3
0to50.0to0.4
Coarsely clumped
Lavenderto colorless 1
:Rare 2
:Lavendertodark purple;variablein numberwithuneven distribution;may obscurenucleusor washoutduring staining,givingthe appearanceof emptyareasin cytoplasm
0to10.0to0.1
*Thedifferenceinsizefromsmalltolargelymphocyteisprimarilyaresultofalargeramountofcytoplasm.See Chapter9 formoredetailed informationonlymphocytesize.
1°,primary; 2°,secondary.
inclusions,suchasD€ ohlebodies,canbeseenatthismagnification.Eachlaboratoryshouldhave establishedprotocolsforstandardizedreportingofabnormalities.
EvaluationoftheRBCmorphologyisanimportantaspectofthefilmevaluationandis usedinconjunctionwiththeRBCindicestodescribecellsasnormalorabnormalinsize, shape,andcolor.Eachlaboratoryshouldestablishastandardreportingprotocol.MostlaboratoriesuseconcisestatementsdescribingoverallRBCmorphologythatisconsistentwiththe RBCindices.ThemicroscopicevaluationofRBCmorphologymustbecongruentwiththe informationgivenbytheautomatedhematologyanalyzer.Ifnot,discrepanciesmustbe resolvedbeforereportingpatientresults.
Thefinalstepintheperformanceofthedifferentialcountistheestimationoftheplatelet number.Thisisdoneunderthe100 oilimmersionobjective.Inanareaofthefilmwhere RBCsbarelytouch,thenumberofplateletsinfivetotenoilimmersionfieldsiscounted.The averagenumberofplateletsismultipliedby20,000toprovideanestimateofthetotalnumber ofplateletspercubicmillimeter.Thisestimateisreportedasadequateiftheestimateisconsistentwithanormalplateletcount,decreasedifbelowthelowerlimitofnormalforthat laboratory,andincreasedifabovetheupperlimitofnormal.Ageneralreferencerangeis 150,000to450,000/mm3 (150–450 109/L).Whenapatientisextremelyanemicorhaserythrocytosis,amoreinvolvedformulaforplateletestimatesmaybeused.
Theestimatecanbecomparedwithanautomatedplateletcountasanadditionalqualitycontrolmeasure.Iftheestimateandtheinstrumentplateletcountdonotagree,discrepancies mustberesolved.Somecausesfordiscrepanciesincludethepresenceofgiantplatelets,many schistocytes(redbloodcellfragments),andplateletsatellitism.Notably,high-quality40 or 50 oilimmersionobjectivescanbeusedbytheexperiencedtechnologisttoperformthe differentialanalysisofthebloodfilm.However,allabnormalfindingsmustbeverifiedunder the100 objective.
SUMMARY Aconsiderableamountofvaluableinformationcanbeobtainedfromproperlyprepared, stained,andevaluatedperipheralbloodfilms.Manylaboratoriesusefilmsmadebythewedge techniquefromEDTAanticoagulatedbloodandstainedwithWrightorWright-Giemsa stain.Thefilmsshouldbeevaluatedinasystematicmannerusingfirstthe10 ,then40 highdryor50 oil,andfinallythe100 oilimmersionobjectivesonthemicroscope. WBCdifferentialandmorphologyandtheRBCmorphologyandplateletestimateare includedinthefilmevaluation.
CHAPTER2 HEMATOPOIESIS Exploring the Variety of Random Documents with Different Content